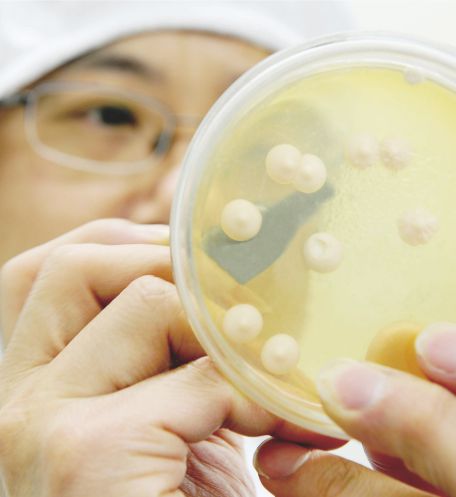
微生物发酵

安琪酵母公司大楼
目录
一、安琪酵母简介

二、发展历程
三、主要领域及产品
(一)面食与烘焙



(二)食品调味
1、酵母抽提物(ye)

2、烹饪调味

(三)生物发酵
(四)营养与健康
1、安琪纽特

2、福邦

福邦logo
福邦是安琪酵母旗下专注于农业领域的统领品牌。福邦针对动物、水产、植物等养殖和种植领域对环保、绿色、安全等需求,开发并推广酵母水解物、酵母代谢物、酵母细胞壁、酵母硒等酵母衍生物和相关应用技术,服务于畜禽、反刍、宠物、淡水和海水养殖、特种养殖、有机农产品种植等多个应用领域。
(五)产业链延伸
1、糖业

2、烘焙设备

3、宏裕塑业

四、安琪酵母优势
(一)科技创新优势

(二)规模优势

(三)品牌优势

安琪酵母是国民熟知品牌
(四)上下游产业链优势
酵母生产的主要原材料是糖蜜,安琪酵母探索上游糖业产业链,自建糖厂,稳定了糖蜜的供应渠道,确保生产原料的充足和稳定。同时,安琪酵母还在国内外布局了多个生产基地,特别是在糖蜜资源丰富的地区,这些地区糖蜜价格相对较低,进一步降低了生产成本。
除糖业务外,安琪在上游还布局酶制剂等业务,开发了酵母、酵母提取物、酵母衍生物等产业,积极发展与酵母应用相配套的食品原料、调味品业务,在下游布局了食品包材等业务,是全球酵母行业产业链发展最完整的品牌之一。
五、国际化布局
(一)海外机构设置

安琪成为海外消费者选择的品牌
(二)海外市场及品牌
六、业绩
2024年, “安琪”品牌价值201.39亿元,位居中国品牌价值评价榜食品加工制造类第三位,品牌强度933,位居第一位。财报数据显示,2024年上半年,安琪酵母实现营业收入71.75亿,同比增长6.86%;实现净利润6.91亿,同比增长3.21%。
七、奖项荣誉

安琪酵母部分荣誉
八、企业社会责任
(一)公司治理
(二)行业发展

安琪举办的赛事
(三)环境保护

(四)公益事业
九、联系安琪酵母
十、参考来源
十一、联系作者
foodtalks什么是系列公司内容策划,用既专业又通俗的方式介绍食品饮料行业的前沿热点。
什么是系列公司内容策划打造企业线上名片,让用户通过一篇文章了解企业的全部!(详细请参考:合作方案 & 合作案例)
内容交流 & 商务合作
yisa
researcher
九游会的联系方式: 86 15618476502

(添加请备注:姓名 公司 职位)
| 项目 | 介绍 | 合作方案 |
|
foodtalks 什么是系列公司策划 |
什么是系列,打造线上的企业名片 |
|
|
fbif & foodtalks 视频策划 |
视频策划,打造企业视频名片 |
|
|
foodtalks 食品雷达 |
已收录6000 家优质企业 |
|
|
更多合作,请点击: |
||
加入foodtalks配料群

(添加请备注:姓名 公司 职位)
关注foodtalks什么是系列公众号

![]()
点击获取更多九游会

 foodtalks
foodtalks
 2,705
2,705

 1
1















